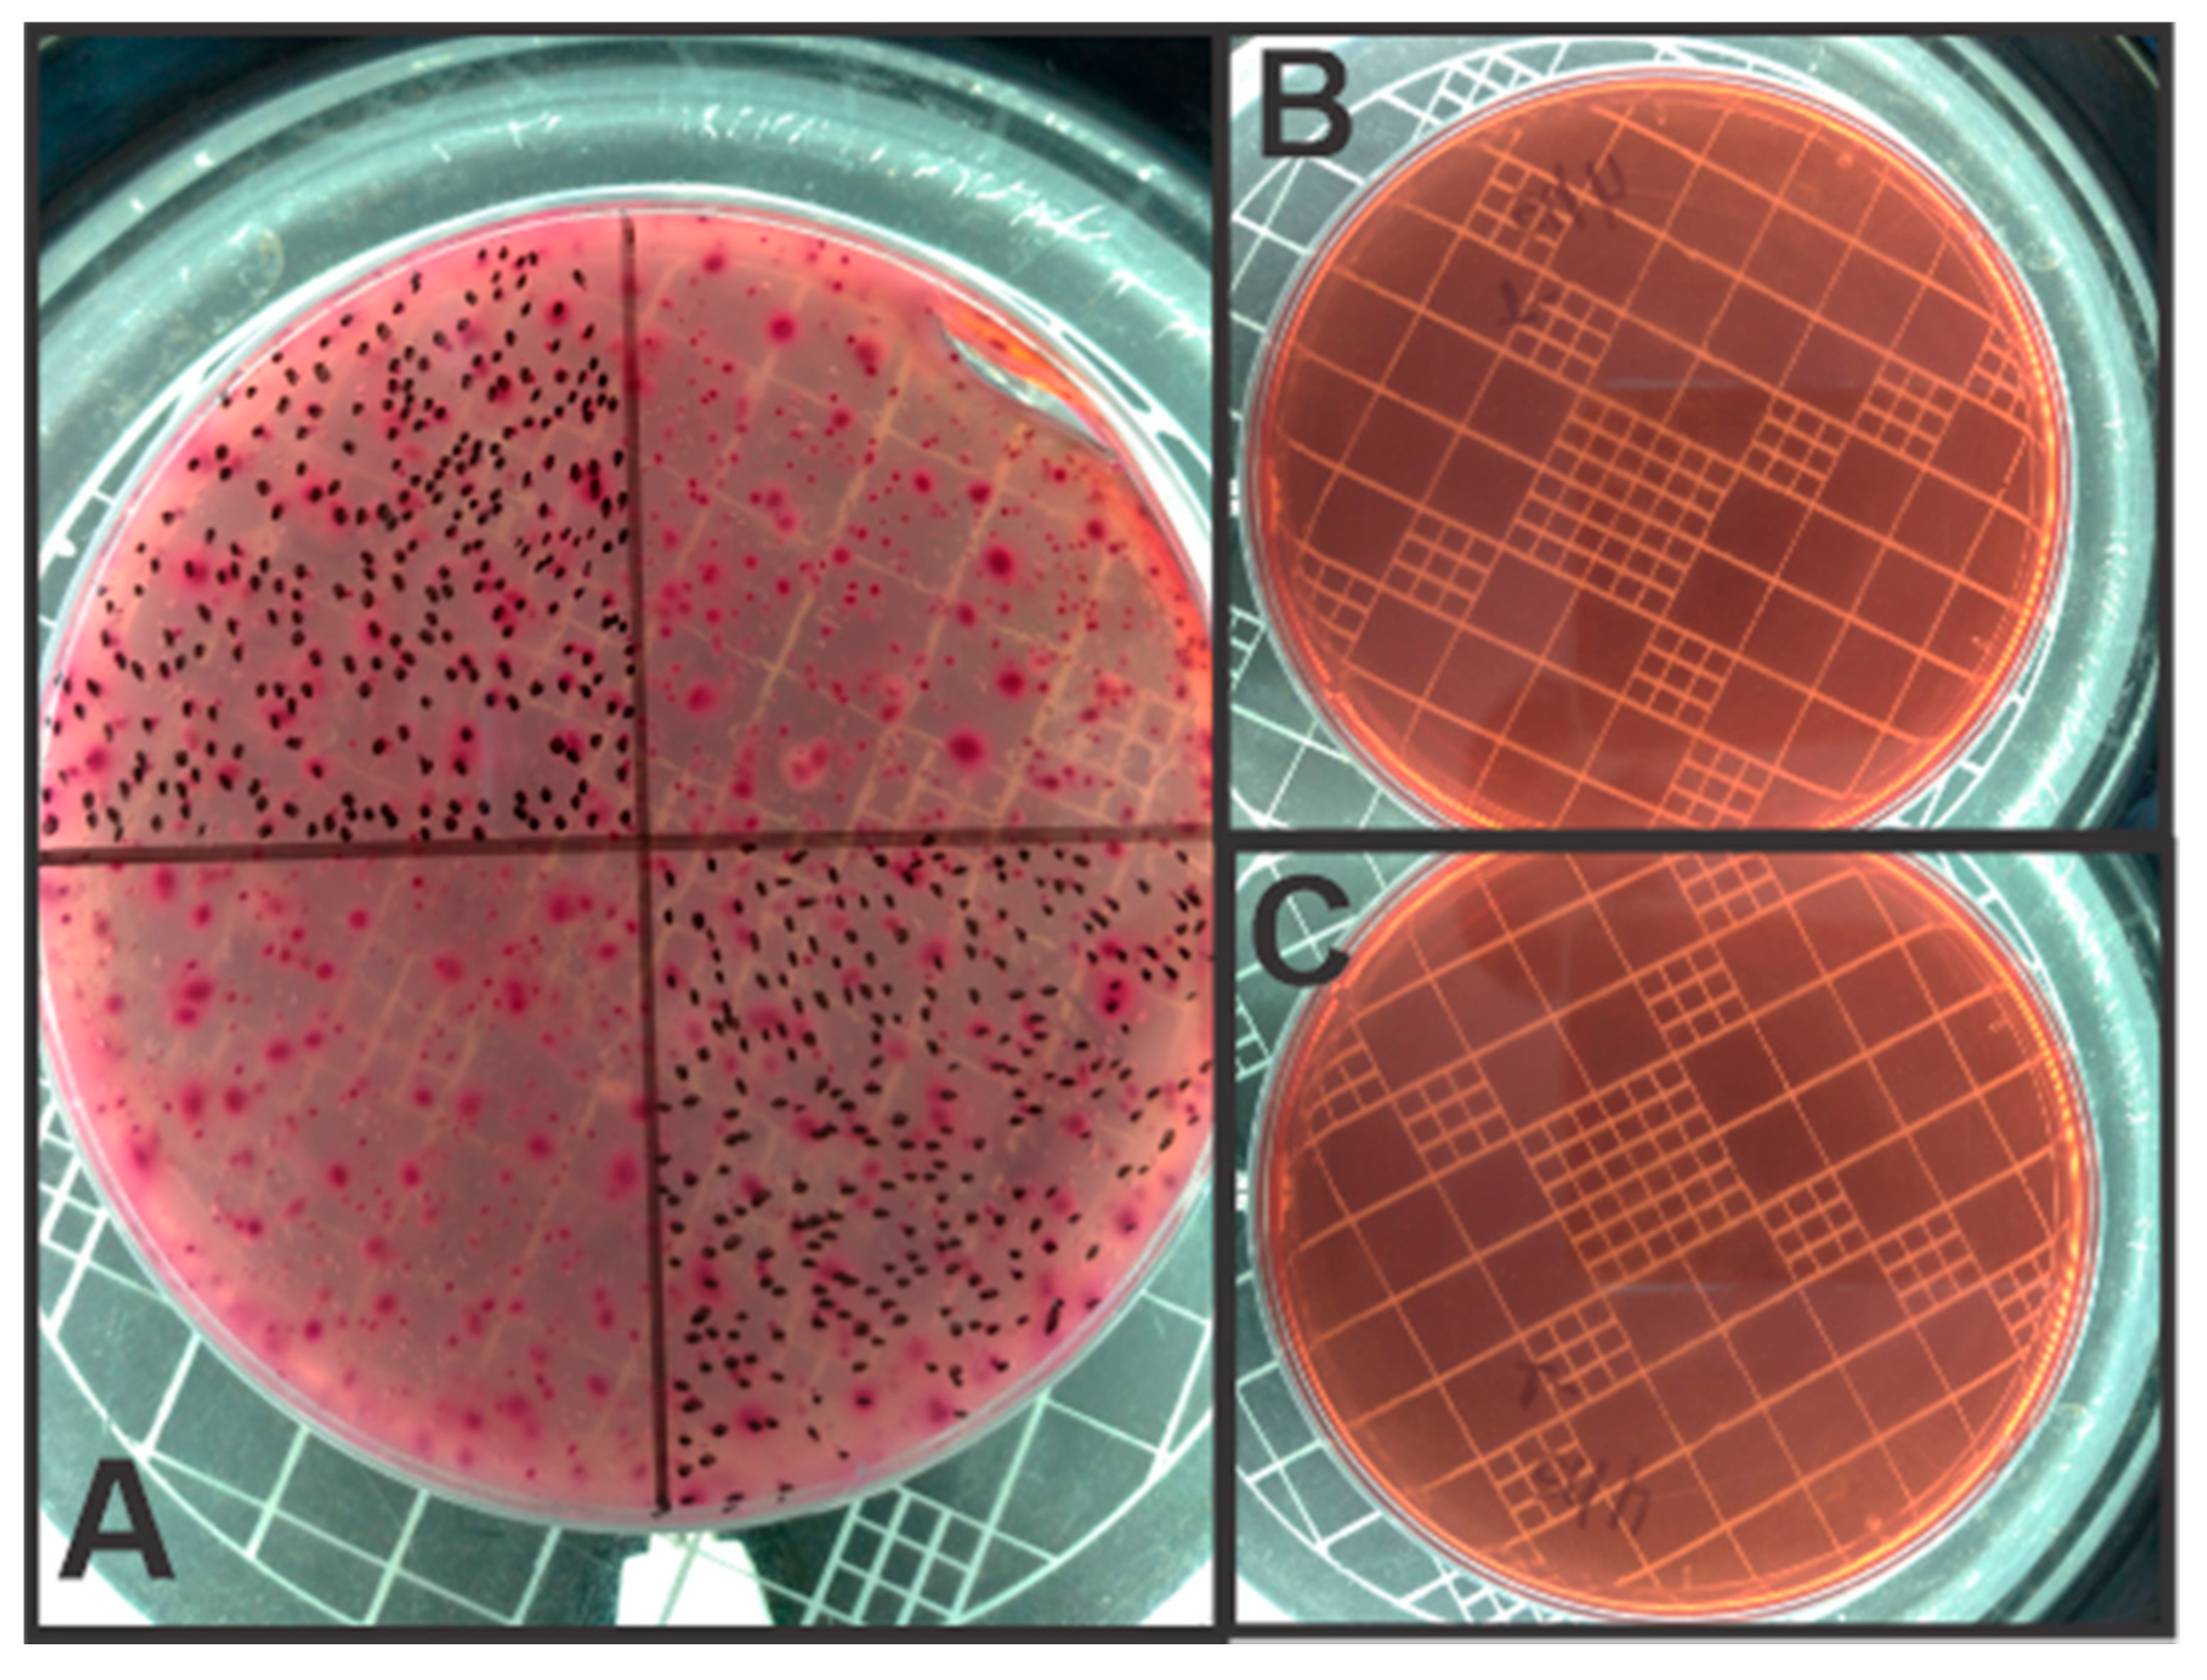
Applsci 11 05009 g004 Applsci 11 05009 g004

Application of Electrocoagulation with a New Steel-Swarf-Based Electrode for the Removal of Heavy Metals and Total Coliforms from Sanitary Landfill Leachate
Abstract
Featured Application
Abstract
1. Introduction
2. Materials and Methods
2.1. Electrode’s Production
2.2. Electrocoagulation Experiments
2.3. Analytical Methods
3. Results and Discussion
4. Conclusions
Author Contributions
Funding
Institutional Review Board Statement
Informed Consent Statement
Data Availability Statement
Acknowledgments
Conflicts of Interest
References
- Fernandes, A.; Ciríaco, L.; Pacheco, M.J.; Lopes, A.; Albuquerque, A. Diagnosis and assessment of the management of sanitary landfill leachates in Portugal. In Proceedings of the WWASTES–Solutions, Treatments and Opportunities II: Selected Papers from the 4th Edition of the International Conference on Wastes: Solutions, Treatments and Opportunities, Porto, Portugal, 25–26 September 2017; CRC Press/Balkema: Boca Raton, FL, USA, 2018; pp. 87–92. [Google Scholar]
- Białowiec, A.; Davies, L.; Albuquerque, A.; Randerson, P.F. Nitrogen removal from landfill leachate in constructed wetlands with reed and willow: Redox potential in the root zone. J. Environ. Manag. 2012, 97, 22–27. [Google Scholar] [CrossRef]
- Costa, A.M.; Alfaia, R.G.; Campos, J.C. Landfill leachate treatment in Brazil—An overview. J. Environ. Manag. 2019, 232, 110–116. [Google Scholar] [CrossRef] [PubMed]
- Deng, Y.; Zhu, X.; Chen, N.; Feng, C.; Wang, H.; Kuang, P.; Hu, W. Review on electrochemical system for landfill leachate treatment: Performance, mechanism, application, shortcoming, and improvement scheme. Sci. Total Environ. 2020, 745, 140768. [Google Scholar] [CrossRef] [PubMed]
- Han, M.; Duan, X.; Cao, G.; Zhu, S.; Ho, S.H. Graphitic nitride-catalyzed advanced oxidation processes (AOPs) for landfill leachate treatment: A mini review. Process Saf. Environ. Prot. 2020, 139, 230–240. [Google Scholar] [CrossRef]
- Yu, X.; Sui, Q.; Lyu, S.; Zhao, W.; Cao, X.; Wang, J.; Yu, G. Do high levels of PPCPs in landfill leachates influence the water environment in the vicinity of landfills? A case study of the largest landfill in China. Environ. Int. 2020, 135, 105404. [Google Scholar] [CrossRef]
- Yi, X.; Tran, N.H.; Yin, T.; He, Y.; Gin, K.Y.H. Removal of selected PPCPs, EDCs, and antibiotic resistance genes in landfill leachate by a full-scale constructed wetlands system. Water Res. 2017, 121, 46–60. [Google Scholar] [CrossRef]
- He, P.; Chen, L.; Shao, L.; Zhang, H.; Lü, F. Municipal solid waste (MSW) landfill: A source of microplastics? -Evidence of microplastics in landfill leachate. Water Res. 2019, 159, 38–45. [Google Scholar] [CrossRef]
- Košutić, K.; Dolar, D.; Strmecky, T. Treatment of landfill leachate by membrane processes of nanofiltration and reverse osmosis. Desalination Water Treat. 2015, 55, 2680–2689. [Google Scholar] [CrossRef]
- Shahedi, A.; Darban, A.K.; Taghipour, F.; Jamshidi-Zanjani, A. A review on industrial wastewater treatment via electrocoagulation processes. Curr. Opin. Electrochem. 2020, 22, 154–169. [Google Scholar] [CrossRef]
- Akhtar, A.; Aslam, Z.; Asghar, A.; Bello, M.M.; Raman, A.A.A. Electrocoagulation of Congo Red dye-containing wastewater: Optimization of operational parameters and process mechanism. J. Environ. Chem. Eng. 2020, 8, 104055. [Google Scholar] [CrossRef]
- Nasser Ghalwa, M.A.; Nader Farhat, B. Removal of Imidacloprid Pesticide by Electrocoagulation Process using Iron and aluminum Electrodes. J. Environ. Anal. Chem. 2015, 2, 1000154. [Google Scholar]
- Mansoorian, H.J.; Mahvi, A.H.; Jafari, A.J. Removal of lead and zinc from battery industry wastewater using electrocoagulation process: Influence of direct and alternating current by using iron and stainless steel rod electrodes. Sep. Purif. Technol. 2014, 135, 165–175. [Google Scholar] [CrossRef]
- El-Ashtoukhy, E.S.Z.; Amin, N.K.; Fouad, Y.O.; Hamad, H.A. Intensification of a new electrocoagulation system characterized by minimum energy consumption and maximum removal efficiency of heavy metals from simulated wastewater. Chem. Eng. Process. Process Intensif. 2020, 154, 108026. [Google Scholar] [CrossRef]
- Zaied, B.K.; Rashid, M.; Nasrullah, M.; Zularisam, A.W.; Pant, D.; Singh, L. A comprehensive review on contaminants removal from pharmaceutical wastewater by electrocoagulation process. Sci. Total Environ. 2020, 726, 138095. [Google Scholar] [CrossRef]
- Galvão, N.; de Souza, J.B.; de Sousa Vidal, C.M. Landfill leachate treatment by electrocoagulation: Effects of current density and electrolysis time. J. Environ. Chem. Eng. 2020, 8, 104368. [Google Scholar] [CrossRef]
- Alinsafi, A.; Khemis, M.; Pons, M.N.; Leclerc, J.P.; Yaacoubi, A.; Benhammou, A.; Nejmeddine, A. Electro-coagulation of reactive textile dyes and textile wastewater. Chem. Eng. Process. Process Intensif. 2005, 44, 461–470. [Google Scholar] [CrossRef]
- Moussa, D.T.; El-Naas, M.H.; Nasser, M.; Al-Marri, M.J. A comprehensive review of electrocoagulation for water treatment: Potentials and challenges. J. Environ. Manag. 2017, 186, 24–41. [Google Scholar] [CrossRef]
- Kobya, M.; Ozyonar, F.; Demirbas, E.; Sik, E.; Oncel, M.S. Arsenic removal from groundwater of Sivas-Şarkişla Plain, Turkey by electrocoagulation process: Comparing with iron plate and ball electrodes. J. Environ. Chem. Eng. 2015, 3, 1096–1106. [Google Scholar] [CrossRef]
- Oliveira, M.T.; Garcia, L.F.; Siqueira, A.C.R.; Somerset, V.; Gil, E.S. Electrocoagulation of the indigo carmine dye using electrodes produced from the compression of metallurgical filing wastes. Int. J. Environ. Sci. Technol. 2020, 17, 1657–1662. [Google Scholar] [CrossRef]
- American Public Health Association; American Waterworks Association; Water Environmental Federation. Standard Methods for the Examination of Water and Wastewater, 19th ed.; APHA: Washington, DC, USA, 1999. [Google Scholar]
- Conselho Nacional do Meio Ambiente Resolução No 430. Dispõe Sobre as Condições e Padrões de Lançamento de Efluentes; Diário Oficial da União: Brasilia, Brasil, 2011. [Google Scholar]
- Kinuthia, G.K.; Ngure, V.; Beti, D.; Lugalia, R.; Wangila, A.; Kamau, L. Levels of heavy metals in wastewater and soil samples from open drainage channels in Nairobi, Kenya: Community health implication. Sci. Rep. 2020, 10, 1–13. [Google Scholar] [CrossRef]
- Al-Musharafi, S.K.; Mahmoud, I.Y.; Al-Bahry, S.N. Heavy Metal Pollution from Treated Sewage Effluent. APCBEE Procedia 2013, 5, 344–348. [Google Scholar] [CrossRef]
- Rad, H.A.; Ziri, M.S.; Babaei, L. Investigation of landfill leachate treatability for reuse in agricultural purposes. Water Pract. Technol. 2017, 12, 224–233. [Google Scholar]
- Kim, T.; Kim, T.K.; Zoh, K.D. Removal mechanism of heavy metal (Cu, Ni, Zn, and Cr) in the presence of cyanide during electrocoagulation using Fe and Al electrodes. J. Water Process Eng. 2020, 33, 101109. [Google Scholar] [CrossRef]
- Hashim, K.S.; Ali, S.S.M.; AlRifaie, J.K.; Kot, P.; Shaw, A.; Al Khaddar, R.; Idowu, I.; Gkantou, M. Escherichia coli inactivation using a hybrid ultrasonic–electrocoagulation reactor. Chemosphere 2020, 247, 125868. [Google Scholar] [CrossRef] [PubMed]
- Kourdali, S.; Badis, A.; Boucherit, A.; Boudjema, K.; Saiba, A. Electrochemical disinfection of bacterial contamination: Effectiveness and modeling study of E. coli inactivation by electro-Fenton, electro-peroxi-coagulation and electrocoagulation. J. Environ. Manag. 2018, 226, 106–119. [Google Scholar] [CrossRef]
- Ricordel, C.; Miramon, C.; Hadjiev, D.; Darchen, A. Investigations of the mechanism and efficiency of bacteria abatement during electrocoagulation using aluminum electrode. Desalination Water Treat. 2014, 52, 5380–5389. [Google Scholar] [CrossRef]
- Wei, V.; Elektorowicz, M.; Oleszkiewicz, J.A. Influence of electric current on bacterial viability in wastewater treatment. Water Res. 2011, 45, 5058–5062. [Google Scholar] [CrossRef] [PubMed]

| Parameters (mg·L−1) | Raw LL | Treated LL | Removal Efficiency (%) | Standard Limits for Treated LL (mg·L−1) | |||
|---|---|---|---|---|---|---|---|
| Brazil a [22] | WHO/FAO 2007 b [23] | India b [23] | Oman c [24] | ||||
| As | 0.06636 | 0.02767 | 59 | 0.5 | * | * | 0.1 |
| Ba | 0.6363 | 0.0498 | 92 | 5.0 | * | * | 1.0 |
| Cd | 0.00412 | 0.00119 | 71 | 0.2 | 0.01 | 1.0 | 0.01 |
| Cr | 0.21614 | 0.10494 | 51 | 0.1 | * | 2.0 | 0.05 |
| Fe | 6.7248 | 1.5082 | 77 | 15.0 | * | * | 1.0 |
| Pb | 0.0547 | <DL | >99 | 0.5 | 5.0 | 1.0 | 0.1 |
| Ni | 10.66 | 0.5030 | 95 | 2.0 | * | 3.0 | 0.1 |
| Zn | 0.3054 | 0.08313 | 72 | 5.0 | 2.0 | * | 5.0 |
Publisher’s Note: MDPI stays neutral with regard to jurisdictional claims in published maps and institutional affiliations. |
© 2021 by the authors. Licensee MDPI, Basel, Switzerland. This article is an open access article distributed under the terms and conditions of the Creative Commons Attribution (CC BY) license (https://creativecommons.org/licenses/by/4.0/).
Share and Cite
de Oliveira, M.T.; Torres, I.M.S.; Ruggeri, H.; Scalize, P.; Albuquerque, A.; Gil, E.d.S. Application of Electrocoagulation with a New Steel-Swarf-Based Electrode for the Removal of Heavy Metals and Total Coliforms from Sanitary Landfill Leachate. Appl. Sci. 2021, 11, 5009. https://doi.org/10.3390/app11115009
de Oliveira MT, Torres IMS, Ruggeri H, Scalize P, Albuquerque A, Gil EdS. Application of Electrocoagulation with a New Steel-Swarf-Based Electrode for the Removal of Heavy Metals and Total Coliforms from Sanitary Landfill Leachate. Applied Sciences. 2021; 11(11):5009. https://doi.org/10.3390/app11115009
Chicago/Turabian Stylede Oliveira, Mayk Teles, Ieda Maria Sapateiro Torres, Humberto Ruggeri, Paulo Scalize, Antonio Albuquerque, and Eric de Souza Gil. 2021. "Application of Electrocoagulation with a New Steel-Swarf-Based Electrode for the Removal of Heavy Metals and Total Coliforms from Sanitary Landfill Leachate" Applied Sciences 11, no. 11: 5009. https://doi.org/10.3390/app11115009
APA Stylede Oliveira, M. T., Torres, I. M. S., Ruggeri, H., Scalize, P., Albuquerque, A., & Gil, E. d. S. (2021). Application of Electrocoagulation with a New Steel-Swarf-Based Electrode for the Removal of Heavy Metals and Total Coliforms from Sanitary Landfill Leachate. Applied Sciences, 11(11), 5009. https://doi.org/10.3390/app11115009

